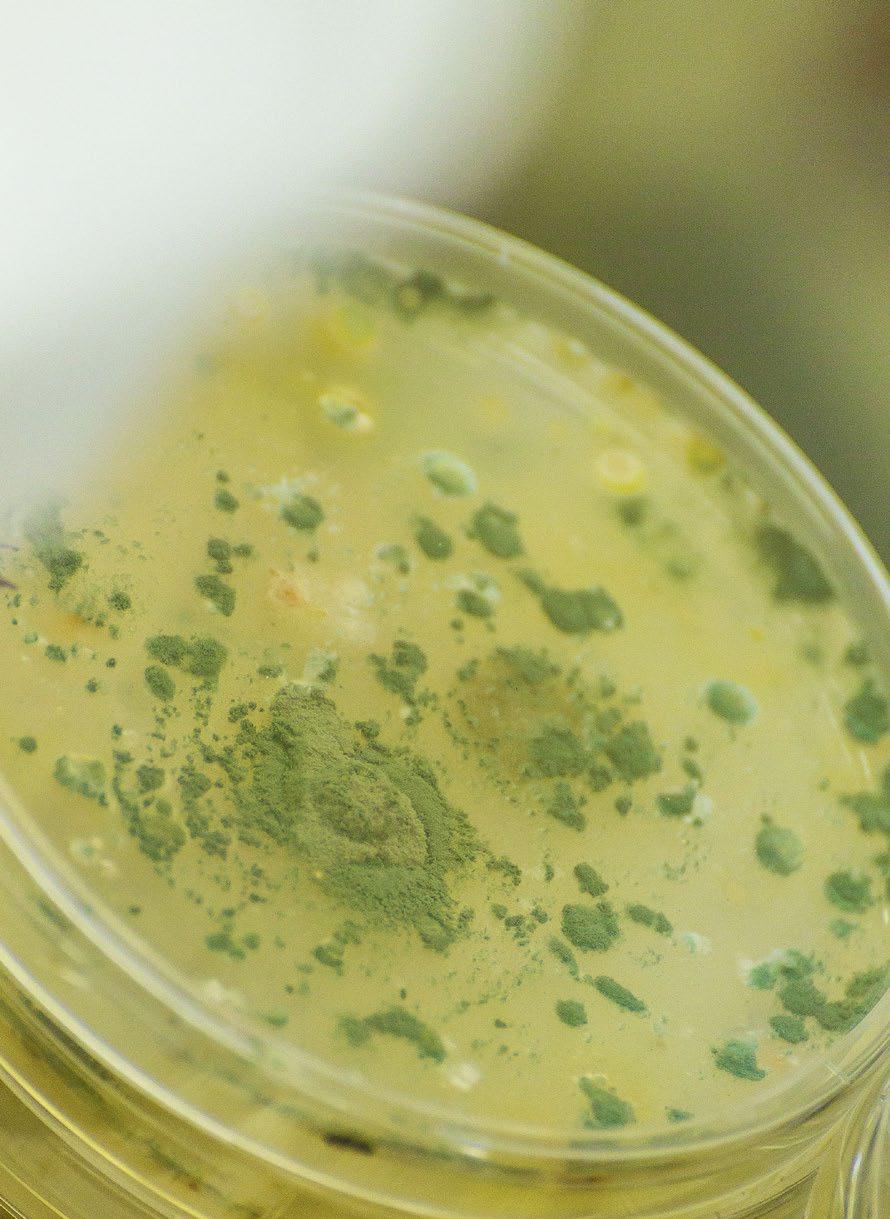

INITIAL GLIMPSE OF MYCOTOXIN LEVELS IN 2022 HARVESTED CORN from
Southeast Europe

1
Jog Raj*, Hunor Farkaš, Svetlana Ćujić, Zdenka Jakovčević, Robert Čepela and Marko Vasiljević PATENT CO, DOO., Vlade Ćetkovića 1A, 24 211, Mišićevo, Serbia
*Corresponding author: jog.raj@patent-co.com
The aim of the present study was to screen corn samples received from different regions of Southeast Europe.
The corn samples from Serbia, Bosnia and Croatia were delivered to PATENT CO’s lab between September 2022 and November 2022
In this survey, 210 corn samples were analysed for multiple mycotoxins by LC-MS/MS triple quadrupole (Agilent 6460 series) using a multi-mycotoxin method for quantification of all mycotoxins present. These included:

Aflatoxins: AFB1, AFB2, AFG1 and AFG2
α-Zearalenol (α-ZEL), β-Zearalenol (β-ZEL), Zearalanone (ZAN), and Zearalenone (ZEN).
Diacetoxyscirpenol (DAS).
HT-2 toxin and T-2 toxin.
3-Acetyl Deoxynivalenol (3-ADON), 15-Acetyl Deoxynivalenol (15-ADON), Deoxynivalenol (DON).
Nivalenol (NIV).
Fumonisins: FB1, FB2 and FB3
Fusaric acid (FA).
Moniliformin (MON).
Ochratoxin A (OTA).
Beauvericin (BEA).
Enniatins: Enniatin A (ENA), Enniatin A1 (ENA1), Enniatin B (ENB) and Enniatin B1 (ENB1).
2
THE COMBINED RESULTS FOR SERBIA, BOSNIA AND CROATIA

ARE SHOWN AS FOLLOWS:

In 2022, 7% of the corn samples from Serbia, Bosnia and Croatia were not contaminated with mycotoxins whereas 93% samples were found to contain more one or more than one mycotoxin (Figure1).
Figure 1. Number of mycotoxins per corn sample from Serbia, Bosnia and Croatia.
< LOQ 1 Mycotoxin >1 Mycotoxin

3
Table 1. Mycotoxin contamination levels (ppb) in corn samples from Serbia, Bosnia, and Croatia in 2022
Mycotoxin Average Maximum Median % Positives
Aflatoxin B1 (AFB1) 121 1126 39 41
Aflatoxin B2 (AFB2) 47 390 13 28
Aflatoxin G1 (AFG1) 18 214 4 13
Aflatoxin G2 (AFG2) 73 337 7 3
Ochratoxin A (OTA) 115 325 92 13
Zearalenone (ZEN) 198 518 114 3
α – Zearalenol (α-ZEL) <LOQ <LOQ <LOQ <LOQ
β – Zearalenol ( β-ZEL) <LOQ <LOQ <LOQ <LOQ Zearalanone (ZAN) <LOQ <LOQ <LOQ <LOQ
3-Acetyl Deoxynivalenol (3-ADON) 123 123 123 1
15-Acetyl Deoxynivalenol (15-ADON) 152 420 109 5
Deoxynivalenol (DON) 269 1587 117 11
Nivalenol (NIV) 146 256 146 1
Fumonisin B1 (FB1) 2,073 16838 1249 79
Fumonisin B2 (FB2) 639 5590 344 68
Fumonisin B3 (FB3) 373 2247 248 52
Fusaric acid (FA) 356 5142 198 83
Moniliformin (MON) 39 281 14 34
Diacetoxyscirpenol (DAS) 8 14 8 5
HT-2 toxin (HT2) 71 362 32 7
T-2 toxin (T2) 39 107 33 6
Beauvericin (BEA) 89 1440 12 68
Enniatin A (ENA) 17 17 17 1
Enniatin A1 (ENA1) 10 12 10 1
Enniatin B (ENB) 15 57 1 3
Enniatin B1 (ENB1) 10 33 4 3
Fumonisins were the dominant mycotoxins detected in 2022 harvested corn from Southeast Europe.
Fusaric acid was detected in 83% of the samples, whereas FB1, FB2 and FB3 were detected in 79%, 68%, and 53% of the samples, respectively.
AFB1 was detected in 41% of the corn samples with an average of 121 ppb.
DON appeared in 11%, OTA in 13% and MON in 34% of the corn samples.
Among emerging mycotoxins Beauvericin was detected in 68% of the corn samples.
4
CONCLUSIONS
In the 2022 harvested corn from Serbia, Bosnia, and Croatia, 93% of corn samples were contaminated with one or more than one mycotoxin.
Fumonisins, Aflatoxins and Beauvericin were the most prevalent mycotoxins detected in these samples using LC-MS/MS.

The co-occurrence of more than one mycotoxin can lead to additive or synergistic effects when fed to sensitive animal species (e.g., swine and poultry amongst others).
This highlights the need for technologies to control mixtures of such contaminants in feedstuffs predominantly based on corn to minimize impacts on animal development.
5